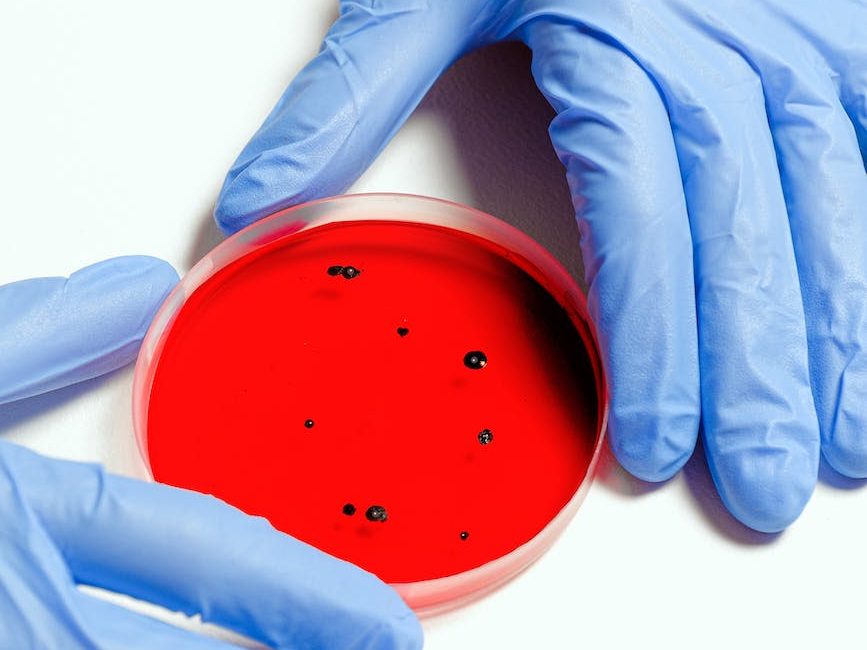

Skills
Culturıng
Proficient
Formal, applied education on cellular, viral, and bacterial culturing as part of the “Basic Sciences” and “Laboratory Medicine” curricula of medical education at the IUE Faculty of Medicine.
104 documented bacterial cultures prepared during my time as Medical Laboratory Intern.

Light and ımmunofluorescence Mıcroscopy
Proficient
Formal, applied education on light microscopy as part of medical education at the IUE Faculty of Medicine.
Informal education and 150 documented wet mount microscopic examinations performed during my time as Medical Laboratory Intern.
Informal, applied education on Immunofluorescence Microscopy during my time as Medical Laboratory Intern

Real-tıme polymerase chaın reactıon
Intermediate
Formal, informal, applied education on Nucleic Acid Amplification Techniques during the “Basic Sciences” and “Laboratory Medicine” curricula of medical education at the IUE Faculty of Medicine.
3 documented SARS-CoV-2 RT-PCR sessions during my time as Medical Laboratory Intern

EEG
Intermediate
Formal, informal, applied education on Electroencephalography measurement and interpretation during Neurology clerkships and internships at the IUE Medical Point hospital.
Informal training on EEG analysis and analysis software (with special focus on Event-Related Oscillations, functional changes during healthy aging and dementia) during time spent as Independent Researcher in the Yener Lab.

Cranıal mrı ınterpretatıon
Intermediate
Formal, informal, applied education on Cranial MRI interpretation during the Radiology clerkship, and Neurology clerkships and internships at the IUE Medical Point hospital.
Informal training on Cranial MRI analysis (with special focus on structural changes during healthy aging and dementia) during time spent as Independent Researcher in the Yener Lab.

Python and r
Beginner
Independent study on the Python and R languages.
Competencies

Clinical reasonıng
Six years of medical education and three years of hands-on experience in clinical care have allowed me to possess an inherent sense for “health”, “disease”, “illness”, “sickness”, and their determinants.
Taking patient history, performing physical examination, and creating a differential diagnosis have almost become second nature to me.

Research methods and ınformatıon management
I received formal training on research methods, data gathering, data analysis, and information management as part of the “Basic Sciences” curriculum of the IUE Faculty of Medicine.
Later on I compounded this training with various independent ventures, seeking research opportunities whenever available. Thanks to my excellent mentors, two of my ventures have resulted in abstract presentations in international conferences, and one has resulted in the publication of my manuscript.

Crısıs management
“Calm” far from the many adjectives one could use to describe the hospital environment. One must always be ready for a sudden crisis, an unexpected emergency patient that demands immediate attention. While healthcare in Turkey is anything but calm, the system can produce professionals that are experts at remaining calm.
I would trust myself without any reservations to be able to work through and resolve crises.

team dynamıcs
One thing that is drilled into the heads of medical students in the IUE Faculty of Medicine is that medical doctors, while indispensable in healthcare, are but one cog in healthcare teams. We do, however, assume de facto leadership of our own teams; being the ones ultimately responsible for the success of care.
The notion that we are meant to be the leaders of our own teams does cause problems, as medical doctors may tend to disregard the opinions and competencies of non-doctor team members.
I have been fortunate enough to be part of many multidisciplinary teams in and out of the work environment; sometimes as the de facto leader, often as a member. I have come to believe that anything worth its merit is the result of cooperation and collaboration; and that the boundaries between disciplines overlap in the most wonderful of ways.

professıonal communıcatıon wıth respect to ıntersectıonalıty and bıas
Nothing is achieved without communicating. The greatest mind with the most revolutionary ideas would be completely wasted without the ability to pass those ideas on.
I have taken part in various projects, workshops, and events; given my fair share of trainings, and attended many conferences and talks. The difference between persons lacking communication skills and persons able to communicate professionally can be likened to the differences between phylogenic species.
My experience has taught me that professional communication is likely to be the most valuable skill an individual can acquire; and that healthy communication can only truly be achieved through intersectionality and mutual acknowledgment of biases.

lıfelong learnıng
I have had a natural curiosity and adored the concept of learning for as long as I can remember. At any given age, one of the most likely things to find me doing was browsing sources of information. (YouTube Documentaries, Wikipedia, Textbooks, PubMed as age appropriate).
As scientists we owe it to the collective wealth of knowledge that has spawned us to pursue it. Only in this chase may we improve ourselves, the world’s collective knowledge, and hopefully the world itself.
I truly believe the pursuit of self-betterment to be as rewarding as it is endless; and that the cruelest form of death is when someone stops growing, or dementia makes them start forgetting.